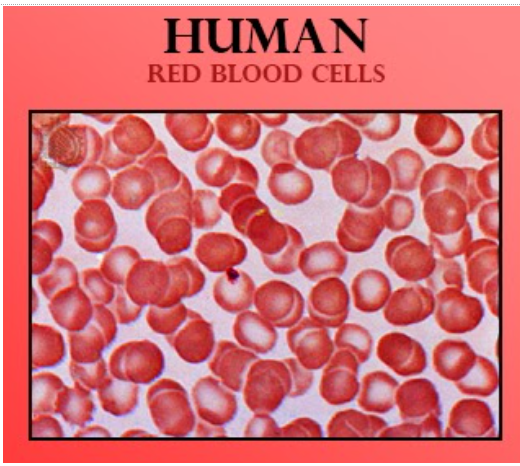
seo images

The average lifespan of human RBC is
(a)100 days
(b)90 days
(c)120 days
(d)None of the above
Answer
603.6k+ views
Hint: They are the cells that do not contain a nucleus and help in the transportation of oxygen.
Complete answer:
Red Blood Cell, one of the most important components of blood has a lifespan of about 120 days. It is destroyed in the spleen and plays an important role in the gaseous exchange in the body.
Additional Information: The life cycle of RBCs consists of Erythropoiesis and Eryptosis.
Erythropoiesis is the process of production of RBCs that takes place in the red bone marrow in adults. It takes about 7 days. The red bone marrows of long bones constantly produce RBCs at the rate of 2 million cells per second. A hematopoietic stem cell found in the bone marrow differentiates into erythrocytes. The RBCs present in the bone marrow have a nucleus which they lose at maturity. In fetal stages, RBCs are also produced in the liver. Erythropoiesis is stimulated by the hormone erythropoietin, this is synthesized by the kidney as feedback to hypoxia. The dietary nutrients that are necessary for the synthesis of hemoglobin are vitamin $B_{12}$ and folic acid. The deficiency of these may cause anemia.
Erypotosis is a form of apoptosis. Programmed cell death of RBCs is brought about by changes in the plasma membrane that make it recognizable by macrophages present in the spleen. The macrophages break down the RBCs by phagocytosis thus continuously purifying blood. It works at the same rate as Erythropoiesis to maintain the RBC number constant. The cycle of one RBC is about 120 days.
So the correct answer is ‘120 days’.
Note: RBCs in camels have a nucleus even in the mature state. Human RBCs not only lack nucleus but also mitochondria for reducing oxygen utilization by the cell itself thus increasing its oxygen-carrying efficiency.

Complete answer:
Red Blood Cell, one of the most important components of blood has a lifespan of about 120 days. It is destroyed in the spleen and plays an important role in the gaseous exchange in the body.
Additional Information: The life cycle of RBCs consists of Erythropoiesis and Eryptosis.
Erythropoiesis is the process of production of RBCs that takes place in the red bone marrow in adults. It takes about 7 days. The red bone marrows of long bones constantly produce RBCs at the rate of 2 million cells per second. A hematopoietic stem cell found in the bone marrow differentiates into erythrocytes. The RBCs present in the bone marrow have a nucleus which they lose at maturity. In fetal stages, RBCs are also produced in the liver. Erythropoiesis is stimulated by the hormone erythropoietin, this is synthesized by the kidney as feedback to hypoxia. The dietary nutrients that are necessary for the synthesis of hemoglobin are vitamin $B_{12}$ and folic acid. The deficiency of these may cause anemia.
Erypotosis is a form of apoptosis. Programmed cell death of RBCs is brought about by changes in the plasma membrane that make it recognizable by macrophages present in the spleen. The macrophages break down the RBCs by phagocytosis thus continuously purifying blood. It works at the same rate as Erythropoiesis to maintain the RBC number constant. The cycle of one RBC is about 120 days.
So the correct answer is ‘120 days’.
Note: RBCs in camels have a nucleus even in the mature state. Human RBCs not only lack nucleus but also mitochondria for reducing oxygen utilization by the cell itself thus increasing its oxygen-carrying efficiency.
Recently Updated Pages
Master Class 11 English: Engaging Questions & Answers for Success

Master Class 11 Social Science: Engaging Questions & Answers for Success

Master Class 11 Maths: Engaging Questions & Answers for Success

Master Class 11 Biology: Engaging Questions & Answers for Success

Master Class 11 Physics: Engaging Questions & Answers for Success

Master Class 11 Chemistry: Engaging Questions & Answers for Success

Trending doubts
One Metric ton is equal to kg A 10000 B 1000 C 100 class 11 physics CBSE

Difference Between Prokaryotic Cells and Eukaryotic Cells

1 ton equals to A 100 kg B 1000 kg C 10 kg D 10000 class 11 physics CBSE

Find the value of the expression given below sin 30circ class 11 maths CBSE

Two of the body parts which do not appear in MRI are class 11 biology CBSE

What are hard magnetic materials class 11 physics CBSE




